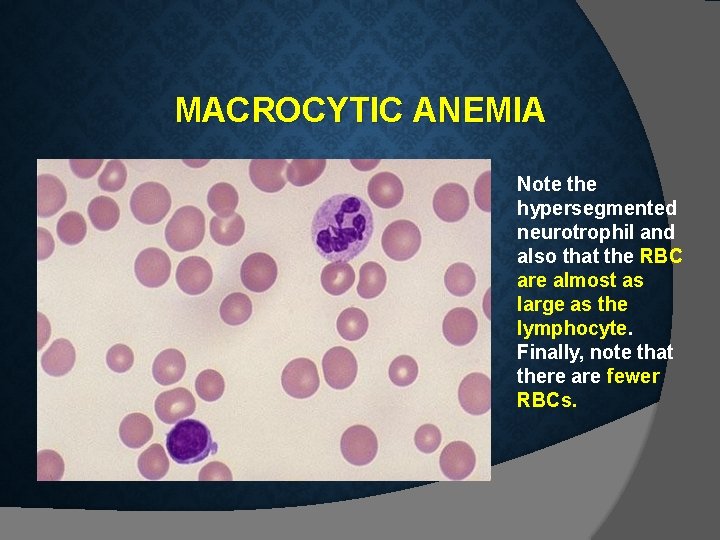

BLOOD PHYSIOLOGY LECTURE 2 Blood Physiology Red Blood

BLOOD PHYSIOLOGY LECTURE 2 Blood Physiology Red Blood cells (RBCs) Dr Nervana Mostafa

OBJECTIVES At the end of this lecture you should be able to: 1. Describe essential elements needed for RBC formation. 2. Describe the process of Vit B 12 absorption and its malabsorption. 3. Recognize haemaglobin structure and its functions. 4. Discuss iron metabolism (absorption, storage and transport) 2

OBJECTIVES – CONT. 5. Describe the fate of old RBC. 6. Describe anemia and its causes. 7. Recognize causes of polycythemia. 3

TOPICS: 1. Essential elements for RBC formation Proteins Vitamins: B 12, Folic acid, Vit C Iron Metabolism. 2. Structure & functions of Hb 3. Anemia 4. Polycythemia

Nutrients required for Erythropoiesis 1 - Amino acids (a. a. ). 2 - Iron. 3 - Vitamins; B 12 (cyanocobalamin) & folic acid [important for DNA synthesis] Vitamin C [important for iron absorption] [present in vegetables & is heat liable as folic acid] Pyridoxine (B 6); [important for haem production its deficiency leads to microcytic hypochromic anaemia] 4 -Trace elements (e. g. cobalt, copper, zinc).

Essential elements for RBCs formation & Maturation 1. Amino acids: formation of globin in haemoglobin - sever protein deficiency anaemia 2. Iron: formation of haemoglobin – Deficiency anaemia 5

VITAMIN B 12 & FOLIC ACID Important for DNA synthesis and final maturation of RBC. Dietary source: meat, milk, liver, fat, green vegetables. Deficiency leads to: Failure of nuclear maturation & division Abnormally large & oval shape RBC Short life span reduced RBC count & Hb Macrocytic (megaloblastic) anemia 7

VITAMIN B 12 METABOLISM

MALABSORPTION OF VIT. B 12 Pernicious Anemia VB 12 absorption needs intrinsic factor secreted by parietal cells of stomach. VB 12 + intrinsic factor is absorbed in the terminal Ileum. • Deficiency arise from (Causes of deficiencies): Inadequate intake Poor absorption due to Intestinal disease 9

HAEMOGLOBIN Hb molecules consist 4 chains each formed of heme & polypeptide chain (globin) 10

Haemoglobin (Hb) = 14 - 16 gm/dl Structure: - Composed of 4 subunits (2 & 2 chains), each unit contains haem (iron-porphyrin). - Iron in the haem is ferrous (fe ²+ ), combines reversibly with oxygen.

* Function of Hb: 1 - carriage of oxygen & carbon dioxide 2 - Buffer.

Types of normal Hb. : -Hb A (2 & 2 beta chains) (adult Hb) (98%). - Hb A 2 (2 & 2 delta chains) (2%) - Hb F (2 & 2 chains) (Hb of intrauterine life). * Abnormality in the polypeptide chain results in an abnormal Hb (hemoglobinopathies) e. g. thalassemias, sickle cell (Hb. S).

FATE OF RBC • RBC life span in circulation = 120 days. • Old cell has a fragile cell membrane, cell will rupture as it passes in narrow capillaries (Reticulo-endotheilal system/Spleen). • Released Hb is taken up by macrophages in liver, spleen & bone marrow: * Hb is broken into its component: 1 -Globin 2 - Haem protein pool. iron (reused) porphyrin is converted to bilirubin. Jaundice 14

FUNCTIONS OF HEMOGLOBIN O 2 & CO 2 transport: Hb reversibly bind O 2 to form oxyhemoglobin. - Carriage of CO 2 Hb bind CO 2 = carboxyhemaglobin Buffer 25

Iron metabolism Total amount in the body = 3 - 5 gm, distributed as follows: 1 - Hb (65 -75%) 2 - storage iron (available) (20%) in the liver, spleen & bone marrow (ferritin). 3 - cellular (non-available). 4 - transport or plasma iron. Iron in food = (10 -20 mg/day) Sources; liver-beef- mutton-fish- egg yolk-beans- lentils & green vegetables. Forms; 1 - organic. 2 - inorganic. Absorption: 1 - Iron in food is in the oxidized form (ferric)(Fe³+), to be absorbed it is reduced to the ferrous state (Fe ²+). • In the stomach: Ferric Hcl Vit C & proteins Ferrous

• Duodenum & upper part of small intestine: - Active transport of ferrous ions at the luminal border. - once in the intestinal mucosal cell iron is attached to a non-ferritin protein carrier & either ; transported across the serosal border to be picked up by transferrin. stored as ferritin by combing with apoferrtin. Iron absorption is dependent on: - Size of iron stores. - Rate of erythropoiesis. Normally, 10 - 15% of ingested iron is absorbed. Iron transport: In plasma; iron now in the ferric form combines to transferrin to form the ferrictransferrin complex. Iron storage = (1 gm) Site: reticuloendothelial cells (liver - spleen - bone marrow) storage forms: ferritin & haemosiderin OR


TRANSPORT AND STORAGE OF IRON Iron is transport in plasma in the form of Transferrin (apotransferrin + iron). Iron is stored in two forms: Ferritin (apoferritin + iron) Haemosiderin (insoluble complex molecule, in liver, spleen, bone marrow) 19

Factors decreasing iron absorption: - Phosphates, phytates & oxalates in diet. - Achlorhydria ( Hcl ) , gastrectomy. - Malabsorption syndromes or chronic diarrhea. Iron excretion: (0. 5 -1. 0 mg) Daily loss of iron is 0. 6 mg in male & 1. 3 mg/day in females. [mainly feces & skin]

Anaemia Definition: Hb concentration below the normal level of the same age and gender. due to 1 - RBCs count below normal level for same age & gender. 2 - Hb load in each RBC (MCH) below normal level. .

BLOOD FILM

Microcytic hypochromic Normocytic normochromic Megaloblastic or macrocytic

Signs and Symptoms: are due to oxygen supply to tissues. - Depending on the severity, the symptoms of anemia may include: • • • Pale skin Fatigue Weakness Tiring easily Breathlessness Postural (orthostatic) hypotension: Drop in blood pressure when standing from a sitting or lying position Frequent headaches Racing heart or palpitations Becoming irritated easily Concentration difficulties Loss of appetite Strange food cravings.

CBC - FBC


CAUSES OF ANAEMIA 1. Blood Loss – acute accident (RBC return to normal 3 -6 w) –Chronic microcytic hypochromic anaema (ulcer, worms) 2. Decrease RBC production Nutritional causes: • Iron microcytic hypochromic anaemia. • Vit B 12 & Folic acid megaloblastic anaemia / pernicious anaemia. Bone marrow failure (Aplastic anaemia): destruction by cancer, radiation, drugs. 3. Haemolytic excessive destruction Abnormal cells or Hb • Spherocytosis • sickle cells Incompatible blood transfusion. Erythroblastosis fetalis.

Causes & Types of anaemias: I- Bleeding: i- Chronic { iron deficiency anaemia} - Menstruation. - GIT bleeding (peptic ulcer- Bilharziasis- piles-hook worms). ii- Acute. (normocytic- normochromic)

II- Decreased production: i- Nutritional deficiency - Iron deficiency leads to (microcytic hypochromic). - Vit. B 12 & folic acid leads to megaloblastic anaemia. v Pernicious anaemia: is a special type of megaloblastic anaemia due to intrinsic factor deficiency causing vit B 12 deficiency. ii – Increased demands (childhood & pregnancy)

iii- Bone marrow failure ---- Aplastic anemia. Due to; a- irradiation or excessive X-ray usage. b- drugs e. g. chloramphenicol. c- invasion of bone marrow by (secondary malignant cells or fibrosis).

III- destruction of RBCs; (Haemolytic anaemia) i- membrane defect spherocytosis.

ii- Abnormal Hb (Hb S) = Sickle cell anaemia

• Haemolytic anaemia (excessive destruction); Abnormal cells or Hb • • Spherocytosis • • sickle cells Incompatible blood transfusion. Erythroblastosis fetalis. Enzymatic defect ------deficiency (G 6 PD): glucose 6 phosphate dehydrogenase G 6 P deficiency is an inherited condition. The body doesn't have enough of the enzyme G 6 PD, which helps (RBCs) function normally. This deficiency can cause hemolytic anemia, usually after exposure to certain medications, foods, or even infections.

MICROCYTIC HYPOCHROMIC ANEMIA - The RBC's are smaller than normal and have an increased zone of central pallor. - This is indicative of a microcytic (smaller size of each RBC) and hypochromic (less hemoglobin in each RBC) anemia. - There is also increased anisocytosis (variation in size) and poikilocytosis (variation in shape).
MACROCYTIC ANEMIA Note the hypersegmented neurotrophil and also that the RBC are almost as large as the lymphocyte. Finally, note that there are fewer RBCs.

Groups at high risk: * Certain people are at increased risk of anaemia, including: - Menstruating women - Pregnant and breastfeeding women - Babies, especially if premature - Children going through puberty - Vegetarians - People with cancer, stomach ulcers and some chronic diseases - People on weight reduction diets - Athletes Treatment: Treatment depends on the cause and severity, but may include: - Vitamin & mineral supplements – in the case of deficiency. - Iron injections – if the person is very low on iron. - Vitamin B 12 oral or by injection – required for pernicious anaemia. - Folic acid suplements - Blood transfusions – if required.


Polycythaemia Increase in the number of RBCs per unit volume of blood. Classification & Causes: 1 - True or absolute; a- primary (Polycythaemia Rubra Vera - PRV) b- secondary, due to hypoxia. 2 - Relative; in cases of dehydration (haemoconcentration)
- Slides: 38